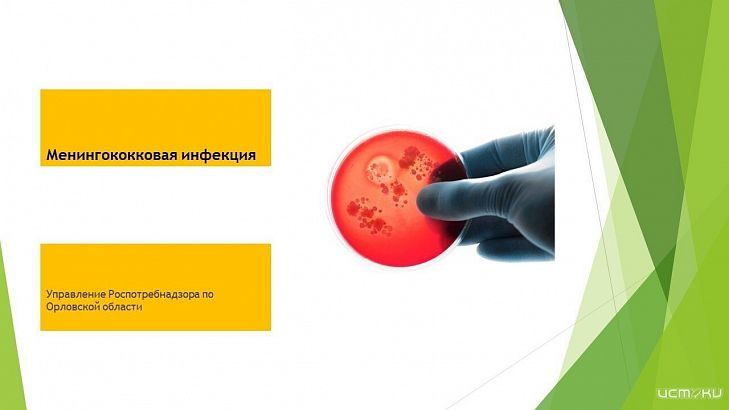
В орловском Роспотребнадзоре прокомментировали сообщения о вспышке менингита

В орловских соцсетях появилась информация о том, что в медицинском колледже вспышка менингококковой инфекции. Ситуацию прокомментировали в Управлении Роспотребнадзора. Там подтвердили, что заболевание выявлено у одного студента.
«За контактными по месту обучения и проживания, сотрудниками медицинских учреждений (БУЗ ОО «Детская поликлиника №3», БУЗ ОО «Поликлиника №1», БУЗ ОО «Детская поликлиника №2», БУЗ ОО «Поликлиника №2») организовано медицинское наблюдение. Проведено лабораторное обследование контактных, результаты лабораторных исследований отрицательные», - сообщили в Управлении.
Организованы и проведены все необходимые профилактические и противоэпидемические мероприятия. На территории региона в 2025 году заболеваемость менингококковой инфекцией не превышает среднемноголетнего уровня, зарегистрированы единичные случаи, групповых очагов не зарегистрировано.